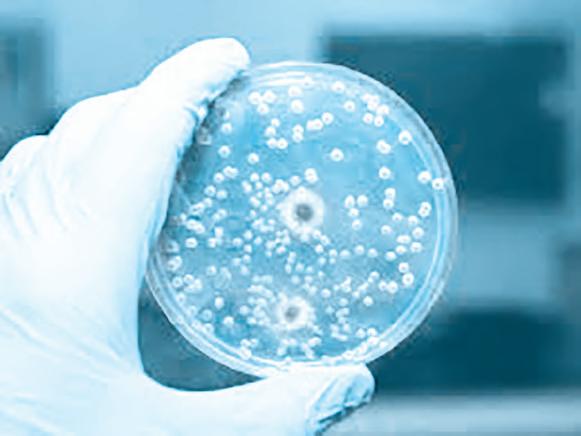

Subject-wise cum Topic-wise Content List
Although this book is based on year-wise pattern, for a quick glance over important topics, this list has been prepared alphabetically under each subject, respectively
PATHOLOGY
AActivated partial thromboplastin time (aPTT) 12
Acute hemolytic transfusion reaction 91
Acute inflammation 55
Acute lymphoblastic leukaemia RP-78, 7, 133 myocardial infarction RP-111, 168 graft rejection RP-80 pancreatitis 67, 177 pyogenic meningitis 118 radiation injury RP-80, 11 transplant Rejection 131
Advanced glycation end products 22
AIDS 75 immune change in 171 opportunistic infections in 151
Alcoholic liver disease 126
Allograft rejection 51
Alzheimer’s disease 111
Amoebic colitis RP-115, 65, 100
Amyloid 131
Amyloidosis 4, 58
Antiglobulin test RP-76
Aortic aneurysm 39
Apoptosis 27, 35, 85 Pathway of 36f
Arachidonic acid metabolites 70
Asbestosis lung 25
Astrocytoma 46
Atheroma 165
Atheromatous plaque 40, 129
Atherosclerosis 79, 178
Autoimmune diseases 173 disorder 119
Autoimmunity 5
Barrett’s esophagus 112
Benign
Gastric ulcer 77
Tumors 51
Beta – thalassemia 151 major 86 trait 27
Bleeding
coagulation factor deficiency 27 platelet defect 27
Blood components RP-101, 59 transfusion 173
BM aspiration 162 Bombay blood group 162 phenotype 135
Bone tumors 110
Bronchial asthma 98
Bronchiectasis RP-84, RP-109, 180
Bronchogenic carcinoma RP-110, 167
Bronchopneumonia 77
Burkitt Lymphoma RP-116, 128
CCaisson’s disease 134
Carcinoids 180
Carcinogenesis chemical 6 radiation RP-103
Carcinoma 171 appendix 141 breast RP-89, RP-114, 165 cervix 100 cardiac edema 28
Celiac disease 68
Cell injury RP-74, 102
Cervical intra epithelial neoplasia 112
Chemotaxis 120
Choriocarcinoma 81
Chronic gastric ulcer 156 pyelonephritis 127 renal failure 21 viral hepatitis 65
Cirrhosis RP-88, 138
Clonal energy 161 deletion 161
Clot 148
CML 88, 133
Coagulation disorder 171
Coal workers’ pneumoconiosis 100
Colorectal carcinoma 123
Complement system 148
Conjugated hyperbilirubinemia 40
Coomb’s test 32
Crohn disease RP-84, RP-107, 39
Cushing syndrome 144
Cytochemistry in acute leukemia 53
DDeficiency anemia 104
Diabetes mellitus RP-107, 161
Diabetic nephropathy 67
DIC (disseminated intravascular coagulation) 54, 91, 149
DNA oncogenic virus 72
Down’s syndrome RP-102, 105
Dysgerminoma 21
Dysplasia RP-75, 116
Dystrophic calcification RP-97, 70
E
Emphysema RP-84, 139
Endocarditis RP-85, 94
Endometrial hyperplasia 61
Erythroblastosis fetalis 71
Erythrocyte sedimentation rate 73, 152
Ewing Sarcoma RP-86, 44
Exudate 4
FFAB Classification of AML 153
Familial adenomatous polyposis coli 114
Fat Embolism 75
Fate of thrombus RP-76
Fatty change liver 102 streak 165
Fibroadenoma 96 breast 18
Fibro congestive spleen 157
Folate deficiency anemia 31
Free radical injury 28
G6 PD deficiency 6, 85
Gall stones 168
Gastric benign 77 chronic 156 diseases 81 malignant 77 ulcer 77
Gaucher’s diseases 104
Germ cell tumors 166
Ghon focus 34
Giant cell tumour of bone RP-112, 95
Glioblastoma multiforme 22
Glomerulonephritis RP-108, 141
Graft versus host disease 92
Granulation tissue 51
Granuloma 51
Grave’s disease 156 H
Haemolytic disease of newborn 13
Hashimoto’s thyroiditis 16, 95
Healing by primary intention 116 secondary intention 116
Hemolysis 70
Hemolytic anemia 116
Hemophilia RP-102, 103 A 131
Hepatitis A 94
B RP-112, 45, 79, 94, 176 C 157, 176
Hepatocellular carcinoma 63 jaundice 4
Hereditary spherocytosis 73
HIV RP-105, 90
Hodgkin lymphoma RP-80, 40 nodular sclerosis 18 lymphocytic depletion 109
H. Pylori 81
Human papilloma virus in neoplasia RP-98, 102
Hydatidiform mole RP-108, 42
Hyperplasia of prostate RP-87, 78
Hypersensitivity reaction RP-74, 70
Hypersplenism 113
Hypovolemic shock 105 I
Immune thrombocytopenia 106, 7, 118
thrombocytopenic purpura 118
Interleukin 107
Intestinal ulcer 16
Intravascular hemolysis 6, 172
Iron deficiency anemia 27, 104
Ischemic acute tubular necrosis 138 heart disease 125
JJaundice 77, 156 laboratory findings 4 pre-hepatic 77 post hepatic 77
Klinefelter syndrome 5
Krukenberg tumor RP-91, 167
Kwashiorkor 27, 135
LLeprosy RP-82, 51
Leukemia 117
Leukemoid reaction RP-104, 4
Lobar pneumonia 77
Lymphoblast 85 M
Malignant gastric ulcers 77 tumor 51
Medullary thyroid carcinoma, 109
Marasmus 27
Megaloblast RP-75, 51, 116
Membranous glomerulonephritis 157
Meningioma RP-113, 139
Metaplasia RP-75, 116
Metastatic calcification RP-97, 70
Microcytic hypochromic anemia 86
Minimal change glomerulonephritis 43
Multinodular goitre 77, 78
Multiple myeloma 8, 107
Myeloblast 85
Myeloid leukemia 4 chronic RP-100, 4
Myocardial infarction 80
Necrosis 27, 30, 85
Neoplasia 52
Nephritic syndrome RP-85, 94
Nephrosclerosis 15
Nephrotic syndrome RP-85, RP-111, 94, 107
Nephrotoxic acute tubular necrosis 138
Neuroblastoma 82
Niemann pick disease RP-77, 57
Nodular sclerosis 18
Normoblast RP-75, 51, 116
Nutmeg liver 23
Obstructive jaundice 4 uropathy 96
Osteogenic sarcoma 19, 78
Osteoporosis 98
p53 gene in neoplasia 36
Paget’s disease 110
Panacinar emphysema 39
Pancytopenia 74
Papillary thyroid carcinoma RP-87, RP-108, 48, 109
Paraneoplastic syndrome RP-100, 88
Pericarditis 156
Phagocytosis 9, 10f
Pheochromocytoma 66
Philadelphia chromosome 58
Platelet disorder 171
Pleomorphic adenoma RP-89, 111
Polyarteritis nodosa 24
Post infectious cirrhosis 97
Primary amyloidosis 4, 33 complex 74
Prostate cancer 62
Protein energy malnutrition RP-79
Prothrombin time 56
Pulmonary embolism 120 tuberculosis 15
Radiation injury 152
Rapidly progressive glomerulonephritis 23
Red infarct RP-97, 162
Renal cell carcinoma RP-92, 158 changes in diabetes mellitus 48 edema RP-82, 132 stones 82
Reticulocyte 118
Retinoblastoma RP-95, 146
Rheumatic heart disease 64
Rheumatoid arthritis RP-93, 41
Sarcoma 171
Secondary amyloidosis 4
Seminoma 99
Septic shock RP-100, 29, 56
Shock 73, 154 stages of 73
Sickle cell anemia 89, 136, 172
Silicosis 113
Special stains for amyloid 131
Spread of tumors 28, 29, 102
Subendothelial infarct 61
Syphilitic aneurysm 39 T
Teratoma 47 ovary 127 testis 179
Testicular tumours 159
Thalassemia RP-81, 54
Thrombocytopenia 7
Transfusion reaction 11
Transmitted diseases 56
Transitional cell carcinoma urinary bladder 45
AAcarbose in diabetes mellitus 294
Acetazolamide, not as diuretic agent 310
Acidic drugs, absorption of 202
Acne vulgaris 295
Acute gout 312 left ventricular failure 288 non-productive cough 233
Adenosine in the treatment of paroxysmal atrial tachycardia 325
Alendronate RP-127, 252
Adequate instructions of patients in treatment with
Agonist and inverse agonist 277
Albendazole in helminthiasis 294
Alcohol dependence 190
Aldosterone in congestive heart failure 244
Alfacalcidol in renal rickets 195
Aliskiren in hypertension 300
Allopurinol in chronic gout 253
Alprazolam in anxiety disorder 274
Alteplase in myocardial infarction RP-142, 282
Aminoglycoside antibiotics in myasthenia gravis 279
Amiodarone in arrhythmias RP-124, 260
Transmural infarct 61
Transplant rejection 172
Transudate 4
Tubercular meningitis RP-94, 123 osteomyelitis 176
Tuberculous meningitis 150 ulcer 94
Tumour markers RP-62, 10
Turner syndrome 33, 86
Typhoid Ulcer 94
UUlcerative colitis RP-84, RP-107, 39 lesions of small intestine 43
Unconjugated hyperbilirubinemia 40
Uroliathiasis 143
Uterine cervix 20
Vegetations of infective endocarditis 15 rheumatic endocarditis 15
Venous thrombosis 32
Viral carcinogenesis 87
Viral hepatitis 20 serological diagnosis 20 meningitis 123
Von Willibrand disease RP-77, 119, 131
WWilms’s tumour 96
Wound healing complications of 10 white infarct RP-97
PHARMACOLOGY
Amphotericin B in fungal infections RP-127, 267
Amyl nitrite in cyanide poisoning 204
Anaerobic microorganisms RP-145 resistance to aminoglycoside antibiotics 329
Angiotensin converting enzyme inhibitors 261
Anovulatory infertility 205
Anti cholinergic drugs 247, 273
Anti diabetic drugs 224
Antianginal drugs RP-121, 187
Antidepressant drugs RP-122, 231
Antiemetic drugs 210
Antihistamines in motion sickness 203
Antimicrobial agents 238 inappropriate use 238
Antimotility drug diphenoxylate is combined with atropine 264
Antipsychotic drugs RP-135, 299
Anti-rabies vaccine 199
Antitubercular therapy 317
Aromatase inhibitors in breast cancer 238
Artemisinin in combination, for malaria RP-142, 223
Artesunate in malaria RP-131, 293
Aspirin in dengue fever 287 in myocardial infarction RP-120, 289
Atorvastatin in coronary artery disease 302
Atracurium in altered hepatic and renal function RP-135, 243
Atropine 273 not preferred for COPD 243
Azathioprine 195
Allopurinol 195
Azithromycin 205
BBAL in arsenic poisoning 331
Basic drugs absorption of 202
Bedaquiline in tuberculosis 197
Beta blockers in angina pectoris RP-120, 257 congestive heart failure 233 contraindication in variant angina 243 lactam antibiotics 280 lactamase inhibitors 228
Bimatoprost in open angle glaucoma 233
Bioavailability 314
Bioequivalence of drugs RP-125, 235
Bisphosphonates in osteoporosis 332
Bromhexine in cough 289
Bupivacaine is preferred for epidural anesthesia during labor 257
Calcium channel blockers 247
Cancer chemotherapy administered in cycles 237
Carvedilol for hypertension 273
Ceftriaxone in typhoid fever 197
Centrally acting muscle relaxants 220
Chemotherapy induced anemia 282 chloramphenicol not for premature neonates 316
Chloroquine in hepatic amoebiasis 238 resistance falciparum malaria 198 resistant malaria 321
Cilastatin along with Imipenem RP-142, 320
Clavulanic acid is used with amoxicillin 316
Clinical significance of plasma protein in binding of drugs 235
Clofazimine in lepra reaction 255
Clomiphene in infertility 296
Clopidogrel in cerebrovascular diseases 209
Clozapine in schizophrenia 313
Combination drug therapy in tuberculosis RP-146, 209
Combination of antitubercular drugs in tuberculosis 281 levodopa with carbidopa in parkinsonism 311
Congestive cardiac failure 274
Corticosteriod in immunological condition 239
Corticosteroid RP-143, 265 not to be stopped abruptly 209 in ulcerative colitis 319
Cross resistance 282
Cyclosporine in organ transplantation 211, 292 renal transplants 333
DDapsone 199
Deferiprone in acute iron poisoning 195 thalassemia 237
Depolarizing neuromuscular blockers 244
Desferrioxamine 268
Desmopressin in diabetes insipidus 218
Dextromethorphan in cough 189
Diabetes mellitus RP-128, 196
Diabetic ketoacidosis 267
Diazepam 286 not for maintenance therapy of epilepsy 309
Digoxin in congestive heart failure 259, 309 Direct thrombin inhibitors 240
Dissociative anesthesia 276
Domperidone as antiemetic agent 306
Dopamine in cardiogenic shock 186, 272
Dopaminergic agonists in Parkinsonism 204
Dosing instructions, of alendronate 223
Doxycycline 227
Drug bioavailability, modified by 191
Drug dependence 206
Drug resistance prevention of 238
Drugs for erectile dysfunction 320 modulating cytochrome P450 enzymes 327 modulating the Renin-Angiotensin system 217 with steep dose response relationship 216
EEmergency contraceptives 334
Enalapril 217, 276, 299 with triamterene, not for CHF 299 enzyme induction significance of 192
Ergometrine not for induction of labour 305 in postpartum hemorrhage RP-127, 281
Erythropoietin in anemia 210
Essential drugs concept 261
Estrogen in combination with progesterone as HRT in postmenopausal women 269
Estro-progestin combination in contraceptives 281
Ethosuximide in epilepsy 259
FFebuxostat in hyperuricemia 198
Fenofibrate in the treatment of hypercholesterolemia 274
Ferrous salts in mild anemia 305
Fibrinolytic agents RP-132, 213
Finasteride in prostatic disease 331
Fixed dose combination 277 of trimethoprim and sulfamethoxazole 270
Fluoroquinolones in tuberculosis 226, 329 fluoxetine 231, 324
Fondaparinux in deep vein thrombosis 226
Furosemide 219 for treatment of pulmonary edema anesthesia RP-120, 231 G
Generalized tonic-clonic-seizures 275
Generic drugs 192
Genetic factors, modifying effect of drug 203
Glaucoma RP-138, 246
Glucocorticoids 305
Gold salts in the treatment of rheumatoid arthritis 300
Gonococcal urethritis 294
Grand mal epilepsy 218
H1 N1influenza 321
HAART 254
Halothane with nitrous oxide for general anesthesia 309
Heparin and warfarin in acute thromboembolic states 329
Heparin RP-146 for both in vitro and in vivo anticoagulation 251
High ceiling diuretics 261
HIV infection 331
Hydroxychloroquine in systemic lupus erythematosis 330
Hypercalcaemia 204
Hypertensive urgency 301
IImipenem 280
Indomethacin for closure of patent ductus arteriosus at birth 270
Inhalational anaesthetic agents 206
Inhaled beclomethasone for Bronchial asthma 272
Inhaled corticosteroids in bronchial asthma 281
Insomnia 260
Insulin 196 analogues 213
Intermittent pulse therapy in cancer chemotherapy 305
Intravenous anaesthetics 207
Inverse agonists RP-140, 248
Ketoconazole RP-132 in syndrome 316
Latanoprost in glaucoma 218
Leflunomide in rheumatoid arthritis 225
Lepra reaction 240, 306
Letrozole in postmenopausal women with breast carcinoma 209
Leuprolide in carcinoma prostate 307, 320
Lignocaine 219 in the management of ventricular arrhythmias 301 with adrenaline for local anaesthesia 186
Linezolid 254 in community acquired pneumonia 211
Liposomal Amphotericin B in Leishmaniasis 255
Live vaccines contraindicated in immune compromised patients 223
Loop diuretics calcium retention 323
Lorazepam over diazepam for treatment of status epilepticus 257
Losartan in Hypertension 245
Low dose aspirin in MI 223, 279
Low dose of ritonavir combined with protease inhibitors like indinavir, saquinavir 264
Low molecular weight heparin for deep vein thrombosis 195
Lugol’s iodine
administered to patients prior to thyroidectomy 297
Macrolide antibiotics 213
Magnesium trisilicate as antacid 307
Manic depressive illness 288
Mannitol as a diuretic 188 in cerebral edema 310
Mast cell stabilizers 295
MDR tuberculosis 332
Mefloquine in malaria 267
Meropenem 200
metformin RP-130, 224
Methadone 234
Methotrexate RP-127, 199 in rheumatoid arthritis 240
Methyl alcohol poisoning RP-123, 301
Metronidazole in amoebiasis 252
Midazolam 313
Mifepristone in termination of first trimester pregnancy 254
Misoprostol in pregnancy 196
Montelukast in bronchial asthma 189
Morphine poisoning 189 not for undiagnosed abdominal pain 285
Multi drug therapy for H. pylori infection RP-131, 279 in the treatment of tuberculosis 240
Myocardial infarction 246
N-acetylcysteine in paracetamol overdose 237
Nitrated in stable angina, not given continuously 244
Nitrates in cyanide poisoning 186
Nitroglycerine 187
OOctreotide in the management of acromegaly 210
Olanzapine 191, 299
Omeprazole 293
Ondansetron 210 as an antiemetic agent 318 in chemotherapy induced vomiting 269
Opioid analgesics 258
Opioids 310
Oral contraceptives 212 failure, in antitubercular chemotherapy 292
Osteoporosis RP-145, 212, 253
Oximes in insecticide poisoning 287
Oxybutynin in urological problems 216
Penicillamine 229
Penicillin is used in rheumatic fever 292
Pentavalent vaccine 214
Pentazocine to be avoided in morphine dependence 216
Peptic ulcer RP-145, 227, 293
Petit mal epilepsy 234
Pharmacogenomics 261
Pharmacovigilance 248
Phenytoin 191
Physostigmine 276
Pilocarpine in glaucoma 259
Plasma concentration of phenytoin rises disproportionately at higher doses 324
Post coital contraceptives 200 contraception 319
Postantibiotic effect 253
Pralidoxime ineffective, as an antidote to carbamate poisoning 231
Prazosin first dose 324
Prednisolone RP-143, 228, 265
Primaquine for causal prophylaxis in malaria 251
Propofol as an anesthetic agent 218
Propranolol in thyrotoxicosis 292, 316
Proton pump inhibitors 319
Pseudoephedrine as a nasal decongestant 272
Pulmonary tuberculosis 317
Pyridoxine along with INH therapy of T-B 307 R
Radioactive iodine 269
Rifampicin 317
Ritonavir 296
Ropinirole in Parkinsonism 285 S
Salbutamol in bronchial asthma 245
Sedative-hypnotic drugs 286
Selective estrogen receptor modulators (SERMs) 252
Severe bronchial asthma 260
Paclitaxel 333
Parenteral route of drug administration is not preferred for routine use 257
Paucibacillary leprosy 211
Sildenafil in erectile dysfunction 310
Sitagliptin in diabetes mellitus 239
Sodium cromoglycate in bronchial asthma 312
Sodium nitroprusside in hypertensive emergencies 203
Spironolactone 234 in edema of cirrhosis of liver 202 heart failure 188, 285
Statins in dyslipidemia 326
Status asthmaticus 219
Subcutaneous route of drug administration, unsuitable in shock 286
Succinylcholine 244 during electroconvulsive therapy 300 causing apnoea 186
Sulfasalazine in rheumatoid arthritis 290
Sulphonylureas in effective in type I diabetes mellitus 279
Sumatriptan in migraine 252, 303
Tamoxifen in breast cancer 226
AAcute pyogenic meningitis 382
Adjuvants 448
Agglutination reactions RP-171, 381
Amoebic liver abscess RP-167, 437
Anaerobic bacteria methods to culture 389
Anaerobiosis 389
Ancylostoma duodenale 396
Antigen antibody reactions 353
Arboviruses 387
Ascaris lumbricoides RP-181, 427
Aspergillosis 364
Autoclave 421
Bacillary dysentery 441
Bacteriological examination of water RP-157, 341
Balantidium coli 406
Biomedical wastes RP-175, 359
C
Candida albicans 396 causing human infections RP-184, 363
Casoni’s test 453
Cell culture techniques 376
Tamsulosin in benign hypertrophy of prostate 232
Tazobactum with piperacillin for severe infections 251
Teratogenicity 220
Terlipressin in bleeding esophageal varices 313
Tetracyclines, not for children 264
Thalidomide lepra reaction 329
Therapeutic applications of plasma half-life RP-125, 220 drug monitoring 248 index 206 window 313
Thiazide diuretics calcium retention 323 in lithium therapy 216
Thyroid storm 302
Thyrotoxic crisis 239
Tizanidine in acute muscle spasm 231
Tocolytic agents 268
Toxic effects of increased dose of phenytoin 299
MICROBIOLOGY
Cell-mediated immunity 439
Chlamydia trachomatis 382
Classical complement pathway 355
Clostidium perfringens 432
Coagglutination 412
Complement fixation test 421
Coxsackie viruses 407
Cryptococcus neoformans 435
Cryptosporidium 435
Dengue fever RP-184, 387
Dermatophytes 428
Dermatophytosis 375
Diagnosis of fungal infections 417 malaria 425 viral diarrhea 429
Dimorphic fungi RP-183, 385
Diphtheria toxin 440
Diphyllobothrium latum 409
Direct demonstration of fungi 445
Drug resistance in bacteria 342, 383 in tuberculosis 357
Toxicity of methotrexate, not dealt with folic acid 264
Trihexyphenidyl in parkinsonism 218
Trimethoprim with sulfamethoxazole 321
Typhoid fever 227
Urinary tract infection 198
Vitamin A preparations 229
Warfarin RP-131, overdosage 289
Zafirlukast in bronchial asthma 233
Zolpidem in Insomnia RP-137, 245
Elek’s gel precipitation test 340
ELISA 401
Enteric fever 340
Enterobius vermicularis 407
Enterococcus 413
Epstein-Barr virus 385
Exotoxin 356
Endotoxin 356
Fever of unknown origin RP-159, 358
Fungi causing oculomycosis 406
Gas gangrene RP-175, 356
Gene transfer in bacteria 400
Gram-negative cell wall 368
Ebola virus 375
Echinococcus granulosus 346
Helicobacter pylori RP-157, 413
Histoplasmosis 385, 428
Hospital acquired infections 370
Hospital associated infections 403
Hot air oven RP-153, 448
Human herpes viruses 435
Human immunodeficiency virus 349
Hydatid cyst 374
Hydatid disease 443
Hypersensitivity 367
Hypersensitivity reactions 338
I
IgA 381
IgM 368
IgM antibody 448
Immunofluorescence 439
Inclusion bodies 453
Intestinal nematodes 373
Laboratory diagnosis of brucellosis 358 cholera 357
Fungal infections 347 kala-azar 362 malaria 374 primary syphilis 431 toxoplasmosis 346 viral infections 365
Larva migrans 444
Leishmania RP-179, 416
Leptospirosis 440
Listeriosis 422
Measles. 408
Meningitis RP-173, 414
Methods of disposal 359 viral cultivation 454
Monoclonal antibodies 339
Mosquito-borne viruses 418
Mycobacteria 448
Mycoplasma 422
Mycoplasma pneumonia 402
NACO guidelines 397
National Immunization schedule of India 378
AAcute arsenic poisoning 495 datura poisoning 463 malathion poisoning 488
Adipocere 460
A girl is 16 years old 507
Air Embolism 521
Arborescent burns RP-200, 510
Non gonococcal urethritis 407
Non–neural rabies vaccines 386
Nontuberculous mycobacteria 341
O
Opportunistic fungal infection in HIV/AIDS RP-165, 444
P
Parasites seen in peripheral blood smear 425
Plasmodium
vivax 443
falciparum 443
Pneumonia 403
Poliomyelitis 445
Polymerase chain reaction (PCR) 450
Post-exposure prophylaxis of HIV RP-168, 418
Prophylaxis against Hepatitis ‘B’ infections 349 polio 419 rabies RP-166, 351
PUO 432
Pulmonary tuberculosis 369, 448
Pulse Polio program 419
Rhinosporidiosis 418
Rickettsial diseases of man 413
Robert Koch 381
Rotavirus 386
S
Salk and Sabin vaccines 408
Scrub typhus RP-156, 389
Significant bacteriuria 433
Slow Virus diseases 436
Sporothrix schenckii 348
Sterilization RP-152 heat 421 moist heat 339
Stool concentration methods 362 techniques 429
Swine influenza 397
Systemic mycoses 417
Taenia solium RP-163, 394
Tissue nematodes 345
Toxins and enzymes produced by Streptococcus pyogenes 370
Transposons RP-154, 389
Treponema pallidum hemagglutination assay RP-155, 369
TRIC agents 449
Type I hypersensitivity 338
Typhoid vaccine 402
Urinary tract infection RP-177, 381
V. cholerae 422
Vector borne parasitic diseases 393 viral diseases 364
Viral vaccines 378
Virulence factors of bacteria 411
Viruses causing diarrhea 386
Viruses transmitted by mosquito 445
Visceral larva migrans RP-165, 385
Water-borne pathogens 341
Wuchereria bancrofti RP-162, 345
Yeasts causing human infections 396
FORENSIC MEDICINE & TOXICOLOGY
BBattered baby syndrome 461
Bite marks 516
Bruise 482
Burking 497
Burns 474
Burtonian line 486
Boy examined is of 14 years 493
Cadaveric spasm 527
Café coronary 507
Carboluria 518
Carbon monoxide poisoning 530
Chronic mercury poisoning 465
Civil negligence RP-196, 464
Complications of criminal abortion 462
Concussion 535
Conduct money 490
Contraindications of gastric lavage 476
Contributory negligence 528
Contusions 535
Criminal negligence RP-196, 464
Cross examination 466
DDactylography 504
Datura and capsicum seeds 534
Dead born 512
Death is due to stampede 468
Defense wound 468
Delhi Medical Council 516
Delirium RP-193, 465
Delusion 494
Dentition 502
Determining the age of injury 490
Diatoms 534
DNA profiling 524
Dribbling of saliva 478
Drowning 473, 488
Dying declaration 470
Entry and exit wounds 465, 529
Exhumation 490
Extradural hematoma 462
Eye change after death 525
Fall from height 523
False virgin 486
Femur 516
Filigree burns 493
Firearms 464
Frost bite 483
Hostile witness 501
Hydrostatic test 527
IImpulse 536
Infamous conduct 469, 508
Infanticide RP-204, 495
Informed consent 494
Injuries 489, 523
Insanity RP-203, 509
Intersex RP-191, 521
Professional Misconduct 488
Negligence 488
Pugilistic attitude 485
Recording of evidence 475
Res ipsa loquitur 504
Ring fracture 533
Rigor mortis RP-192
Joule burn 505
duties of a doctor in 487
Ligature Marks 530
Lochia RP-202, 508
Lucid Interval 501 M
Medical Council of India 517
Medical negligence 474, 482
Medicolegal autopsy 470
Methyl alcohol poisoning RP-202, 479, 495
M’Naghten Rules 476
Modern concept of moment of death 461
Morphine poisoning 514
MTP Act RP-196, 1971 518
Mummification 478
Sadism 483
Scalds 535
Scar marks 513
Signature fracture RP-200, 479
Skulls 482
Snakes 502
Sodomy 501
Somniferous poisons 529
Statutory rape 497
Strangulation 503
Strychnine poisoning 509
Stupefying agents 462
Subpoena 490
Tattooing 468
Tattoo marks 514
Teeth bites 523
Testamentary capacity 528
Thermal injuries 530
The boy is 21 years of age 485
The girl is 18 years of age 460
Traumatic asphyxia 512
Organophosphorus poisoning RP-193, 472
Umbilical cord strangulation 468
Universal antidote 480
Gustafson’s method 487
Patterned injuries 512
Perjury RP-197, 510
Person is 12 years of age RP-200, 533
Pelvis, differentiation RP-204, 463
Vicarious responsibility RP-207, 497
Habitual passive agent 461
Hallucination 518
Heat hematoma 474
Hesitation cuts 500
Homicidal and suicidal cut throat injury 464
Phenol poisoning or carbolic acid poisoning 481
Poisoning 487
Poisons RP-193, 471, 481
Privileged communication 480
Warning notice 525 Whiplash injury 482